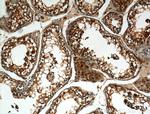
ALDH1A2 Antibody in Immunohistochemistry (Paraffin) (IHC (P))

Search
Proteintech
ALDH1A2 Polyclonal Antibody
{{$productOrderCtrl.translations['antibody.pdp.commerceCard.promotion.promotions']}}
{{$productOrderCtrl.translations['antibody.pdp.commerceCard.promotion.viewpromo']}}
{{$productOrderCtrl.translations['antibody.pdp.commerceCard.promotion.promocode']}}: {{promo.promoCode}} {{promo.promoTitle}} {{promo.promoDescription}}. {{$productOrderCtrl.translations['antibody.pdp.commerceCard.promotion.learnmore']}}
产品信息
13951-1-AP
种属反应
已发表种属
宿主/亚型
分类
类型
抗原
偶联物
形式
浓度
规格
纯化类型
保存液
内含物
保存条件
运输条件
产品详细信息
Immunogen sequence: GQIIPWNFP LLMFAWKIAP ALCCGNTVVI KPAEQTPLSA LYMGALIKEV GKLIQEAAGR SNLKRVTLEL GGKSPNIIFA DADLDYAVEQ AHQGVFFNQG QCCTAGSRIF VEESIYEEFV RRSVERAKRR VVGSPFDPTT EQGPQIDKKQ YNKILELIQS GVAEGAKLEC GGKGLGRKGF FIEPTVFSNV TDDMRIAKEE IFGPVQEILR FKTMDEVIER ANNSDFGLVA AVFTNDINKA LTVSSAMQAG TVWINCYNAL NAQSPFGGFK MSGNGREMGE FGLREYSEVK TVTVKIPQKN S (181-481 aa encoded by BC030589)
靶标信息
This protein belongs to the aldehyde dehydrogenase family of proteins. The product of this gene is an enzyme that catalyzes the synthesis of retinoic acid (RA) from retinaldehyde. Retinoic acid, the active derivative of vitamin A (retinol), is a hormonal signaling molecule that functions in developing and adult tissues. The studies of a similar mouse gene suggest that this enzyme and the cytochrome CYP26A1, concurrently establish local embryonic retinoic acid levels which facilitate posterior organ development and prevent spina bifida. Three transcript variants encoding distinct isoforms have been identified for this gene.
仅用于科研。不用于诊断过程。未经明确授权不得转售。
生物信息学
蛋白别名: AL1A2; alcohol dehydrogenase family 1, subfamily A2; alcohol dehydrogenase family 1, subfamily A7; aldehyde dehydrogenase 1A2; Aldehyde dehydrogenase family 1 member A2; aldehyde dehydrogenase family 1, subfamily A2; ALDH1A2; RALDH 2; RALDH(II); ralDH2; Retinal dehydrogenase 2; retinal dehydrogenase, type II; retinaldehyde dehydrogenase 2; Retinaldehyde-specific dehydrogenase type 2; unnamed protein product
基因别名: ALDH1A2; Aldh1a7; AV116159; DIH4; RALDH(II); Raldh-2; Raldh1; RALDH2; RALDH2-T
UniProt ID: (Human) O94788, (Mouse) Q62148, (Rat) Q63639
Entrez Gene ID: (Human) 8854, (Mouse) 19378, (Rat) 116676